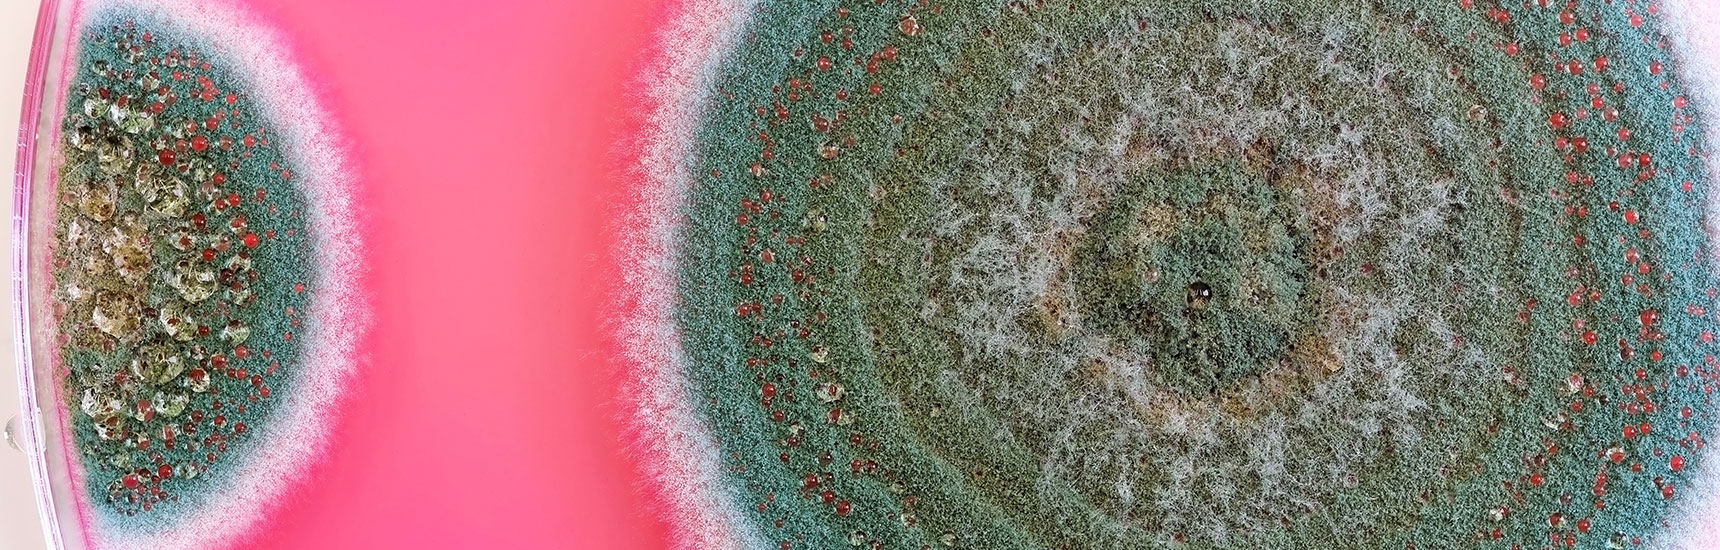
Pilz auf Petrischale - TopMicrobialStock/AdobeStock

Klimawandel und Katastrophen: Wie sich Pilzerkrankungen ausbreiten
Der Klimawandel und seine Folgen schlagen sich in verschiedenen Bereichen nieder. Auch die Medizin bzw. unsere Gesundheit bleiben von den Folgen der sich ändernden klimatischen Bedingungen nicht verschont. Eine neue wissenschaftliche Arbeit, die im renommierten Journal „Lancet“ erschienen ist, beschäftigt sich mit der Frage, wie sich Klimawandel, Katastrophen und soziale Faktoren auf die Verbreitung von Pilzerkrankungen weltweit auswirken. Für die Med Uni Graz war Martin Hönigl von der Klinischen Abteilung für Infektiologie an der Studie federführend beteiligt. Die Arbeit zeigt auf, wie der Klimawandel eine Zunahme von Pilzinfektionen begünstigt und dass systematische, global koordinierte Interventionen notwendig sind, um dieses Problem in den Griff zu bekommen.
Pilze und Klimawandel
Der Klimawandel verändert die Welt, und ihre Bewohner*innen müssen sich mit ihr verändern. Das trifft nicht nur auf uns Menschen zu, sondern auch auf andere Lebewesen wie Pilze. Die Durchschnittstemperatur in der Atmosphäre steigt, das Klima wandelt sich und sehr anpassungsfähige Pilze gewöhnen sich schnell an diese neuen Bedingungen. Dies hat nicht nur zur Folge, dass krank machende Pilze sich in wärmer werdenden Gebieten ausbreiten, sondern auch, dass sich Pilze im Extremfall auch an die Temperaturen am und im menschlichen Körper anpassen können. Das wiederum führt dazu, dass neue Pilze wie Candida auris Infektionen bei immungeschwächten Personen hervorrufen und sich in weiterer Folge weltweit ausbreiten können.
Pilze und Naturkatastrophen
Der Hauptfokus der Studie lag allerdings nicht auf dem Klimawandel, sondern seinen direkten (und indirekten) Folgen. So führen andere klimatische Bedingungen zu vermehrten Naturkatastrophen, die erwiesenermaßen Pilzerkrankungen in der Bevölkerung hervorrufen. Von Pilzausbrüchen nach Naturkatastrophen wurde bisher am häufigsten aus den USA und Südostasien berichtet, was aber einerseits daran liegt, dass dies Regionen sind, in denen relativ häufig Naturkatastrophen vorkommen, andererseits verfügen sie auch über die medizinische Grundausstattung, diese Erkrankungen akkurat auch in einer Katastrophensituation zu diagnostizieren. Es ist davon auszugehen, dass Pilzerkrankungen weltweit nach Katastrophen häufiger werden, Infrastrukturen und Ressourcen zur Diagnose in den nach Naturkatastrophen überforderten Gesundheitssystemen aber oft fehlen.
Die Gründe für die vermehrten Infektionen sind vielfältig. Unter anderem werden durch die Katastrophen selbst Sporen verteilt. Winde oder Waldbrände führen dazu, dass sie freigesetzt und stärker verteilt werden. Dies ist zum Beispiel bei Feuerwehrleuten zu sehen, die bei Waldbränden im Einsatz sind, welche im Anschluss Pilzerkrankungen aufweisen, oder in Küstenregionen in denen nach Waldbränden eine höhere Rate an Pilzerkrankungen bemerkbar ist, nachdem Sporen durch die Brände über die Luft verteilt wurden.
Zusätzlich kommt es infolge von Katastrophen natürlich auch bei Menschen zu Traumata oder auch schweren Verletzungen, die sie wiederum anfälliger für eine Infektion machen. Und auch auf lange Zeit gesehen können Katastrophen nachwirken: Häuser werden infiziert und beispielsweise durch Flutungen zum perfekten Habitat für Pilze, die sich dann über Jahre oder Jahrzehnte im Gemäuer breit- und die Bewohner*innen krank machen können.
Ein Apell für die Gesundheit
Martin Hönigl ist hauptkorrespondierender Seniorautor, hat das Projektteam zusammengestellt und den Senior Lead für den Part „Natural Disasters“ übernommen. Ebenfalls für die Med Uni Graz hat Matthias Egger von der Klinischen Abteilung für Infektiologie am Paper mitgearbeitet. Sie geben einen Ausblick, welche Schritte notwendig sind, um in Zukunft die mit dem Klimawandel einhergehenden Herausforderungen im Bereich der Pilzinfektionen in den Griff zu bekommen. „Neben allgemeinen Maßnahmen zur Bekämpfung des Klimawandels sind die global koordinierte Bereitstellung von Ressourcen für die Überwachung von Pilzinfektionsausbrüchen, die Verbesserung der diagnostischen Kapazitäten, das Training von Gesundheitsfachkräften und öffentliche Sensibilisierungskampagnen unerlässlich“, schließt Martin Hönigl ab.
Steckbrief: Martin Hönigl
Nach seiner Habilitation zum Thema systemische Pilzinfektionen im Jahr 2012 und einem mehrjährigen Auslandsaufenthalt an der Abteilung für Infektionskrankheiten an der University of California San Diego ist Martin Hönigl nun seit 2021 Assoziierter Professor für Translationale Mykologie an der Medizinischen Universität Graz. Hönigl ist Autor von über 300 wissenschaftlichen Publikationen.
Kontakt

Klinische Abteilung für Infektiologie
Medizinische Universität Graz